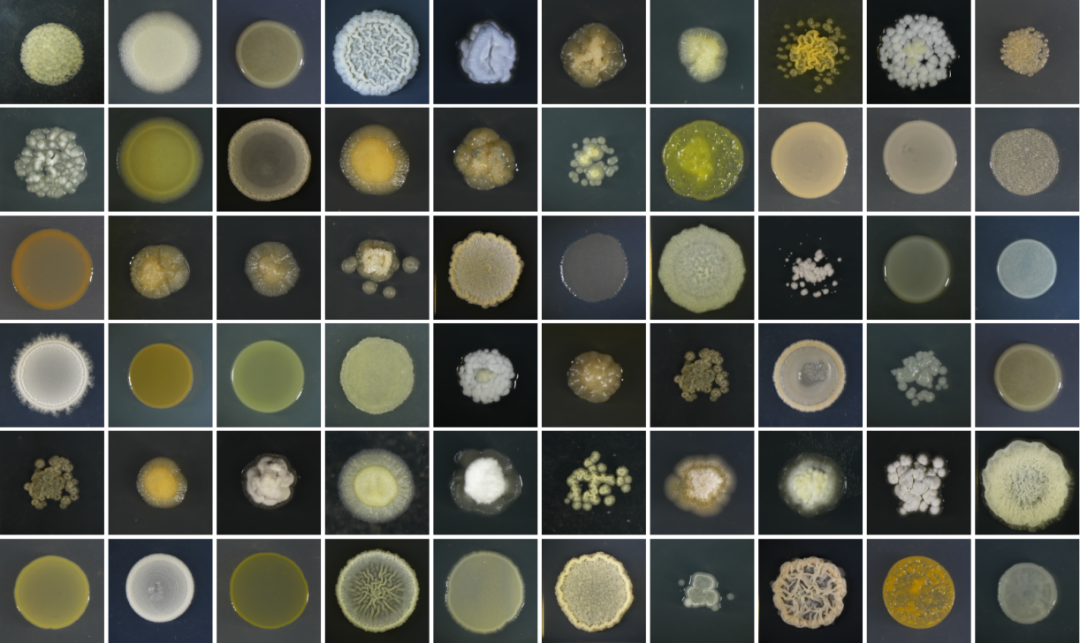

松软的面包、劲道的面条喷香的馒头、酥脆的饼干......这些我们爱吃的美食都来源于一种粮食作物——小麦然而这种主粮作物却深受赤霉病的危害威胁我国粮食安全和食品安全
如何解决小麦“传染病”让人们吃到放心的面点?浙江大学农业与生物技术学院资源利用与植物保护专业2021级硕士生孙加鑫提出“以菌治菌”的生物防治方案在麦田土壤中成功分离出高效防控小麦赤霉病的生防菌株在基础研究和产业应用方面都体现出巨大潜力为防治小麦“传染病”提出了“新药方”
千挑万选,挖掘防病害“好苗子”“情况看起来确实比没喷菌剂的好了很多,腐烂和红色霉层的症状都轻了很多。”孙加鑫收完最后一捆麦子后直起身,脸上露出满意的微笑。
时间追溯到2021年,孙加鑫刚刚进入浙大校园,开启研究生生涯。一心学农的他,总想运用自己的专业知识,为国家的农业生产做点事情。他将目光投向了我国重要粮食作物——小麦。
小麦赤霉病是当前制约我国小麦产业发展的重大真菌病害,全国年均发病面积约占总种植面积的20%,严重威胁小麦生产安全;同时,病菌侵染小麦过程中还会产生呕吐毒素等真菌毒素,危害食品安全。该病害已被农业农村部列为一类农作物病害。
生物防治是植物保护领域的一个热点概念,即利用有益生物抑制有害生物,从而防止病害对作物造成的不良影响。
孙加鑫便是看到了“生物防治”方法在植物病害防治领域的潜力和前景。在农业与生物技术学院小麦病害研究团队负责人马忠华教授的支持、导师陈云教授的指导下,他开始围绕“小麦赤霉病生防资源挖掘与利用”展开了相关研究。
万事开头难。为了能更加广泛收集对赤霉病菌具有潜在拮抗作用的菌种,2022年3-5月,孙加鑫去往江苏、安徽两省共19个县市,收集当地农业试验田里的水稻、麦子和玉米的秸秆样本。
在这些样本中,孙加鑫共分离得到6622株可培养微生物。在对这六千多个菌株进行抑菌活性评价后,他惊喜地发现有600多株菌有抑菌作用,其中12株菌在学术界研究较少。这12株菌便成为孙加鑫主要的研究对象。
“分离和筛选菌株是一项重复性很高的工作,有时候会觉得很枯燥,但我想着既然要做,就要做好,也就一直坚持下来了。”孙加鑫回忆实验过程时感慨道。
导师陈云教授时刻关注他的实验进度,与他讨论结果并提出下一步实验建议,同时也给他提供精神上的鼓励和支持。“我做的培养基很多,有时候未及时更换培养基,陈老师就会提醒我,避免之前的工作白费。他也会关心我的生活,发现我状态不太好的时候会停下工作和我聊天,安慰开解我。”
实践是检验实验结果的最佳途径。除了在实验室培养分离菌株,陈云教授还鼓励孙加鑫深入麦田,实地测试菌种的防病效果。“这才是解决产业问题和开发实际应用技术的关键。”
为保证最好的防治效果,2023年4-6月,孙加鑫争分夺秒,抓住小麦扬花的窗口期,在最短的时间内再次造访安徽、江苏、山东三省的小麦农业实验田,将制成的菌剂喷洒到试验田的小麦上,观察实际防病效果,以验证菌种的有效性。
“一个月之内跑三个省份多个试验点,一个月后小麦成熟,再收集喷过菌剂的秸秆,根据小麦的田间表现筛选出有实际效用的菌种。”孙加鑫回忆道,“尽管从喷药到验证统计发病情况之间间隔一个月,但因为需要在三个不同省份的麦田分别试点,往往刚刚在山东喷完菌剂,又要跑回江苏,统计调查麦田的生防效果。”期间,孙加鑫基本天天扛着各种农艺工具穿行在麦子中,常常双脚不离土地,在田里一待就是一整天。
令人振奋的是,经过实验验证,细菌中有6株链霉菌的防病害减毒素效果都超过了70%;生防青霉菌株Pa810的田间防效也超过了50%,这也是首次发现该类真菌可用于赤霉病防控,为赤霉病生物防治提供了新资源。
同时,在导师的指导下,孙加鑫研发了生物防治与化学杀菌剂协同防控赤霉病的技术,田间防效超过85%,且化学农药使用量降低20%以上。该成果获得浙江省专业学位研究生优秀实践成果。陈云教授将这一成果结合长期积累的生物防治经验总结提炼后撰写成报告,得到国家有关部门的关注。“以所学所研服务国家战略,面向现实需求,这是知识分子最大的价值。”当提起这一成果时,孙加鑫非常自豪。
忙碌的同时,外出奔走的工作也给孙加鑫带来了不一样的体验。麦田里的实地工作和实验室的基础研究有很大的区别,他需要独立完成器械准备、交通出行、联络对接等一切事宜。“这在一定程度上锻炼了我时间规划的能力。”在提起这段经历的收获时,孙加鑫如此说道。
立足刚需,展现新农人“强担当”农业生产面临病虫害严重威胁,传统化学农药的长期使用虽然有效控制了病害,但也带来了诸多负面影响,包括农产品农残超标、生态环境破坏以及病原菌耐药性等问题。
此外,公众对农产品安全和生态保护的需求日益增强,绿色农业逐渐成为全球农业发展的主流方向。利用有益微生物资源开展作物病害的生物防控,是植物有害生物绿色防控的重要举措,是绿色农业发展的重要支撑。
孙加鑫来自农村,从小在田里长大的他在熟悉农事劳动的同时,也对农业科学有着强烈的向往,从学习农学的基本知识开始,便想着把自己的所学都应用到实际生产中。他深知,任何科学研究都是一个长期的过程,除了要考虑层出不穷的现实问题,还有理论与实践间的差距,这考验的是研究者的耐心和反思总结能力。
就在去年,孙加鑫申请了硕士转博士,不仅是为自己的研究生涯“续费”,更是想要圆一个为农业生产事业贡献力量的梦。
“生防研是需要功夫下到一定程度才能有成果。我选择转博,正是想在浙大这样一个高水平研究平台上,把自己想做的课题研究再深入下去,真正做出一些能够响应国家需求、人民需求的成果,不想就此匆忙结束,浅尝辄止。”孙加鑫坚定地说道。
除了自身的发展,孙加鑫还热衷于将自己对农学的热爱传递给学弟学妹。他协助陈云教授指导的本科生及研究生开展的创新项目“以赤心防赤病—打造小麦赤霉病新良方”,在第十九届“挑战杯”全国大学生课外学术科技作品竞赛2024年度“揭榜挂帅”专项赛中斩获特等奖 。
目前,孙加鑫正带领两名本科生进行科研训练项目和毕业设计,将自己在做实验时积累的经验传授给他们,为他们今后的发展铺路。“我在教他们怎么做实验的时候,也从他们的身上学到很多,算是一种教学相长的过程吧。”
在鼓励中成长,在实验中探索真知,孙加鑫将带着心中的愿望,在小麦生物防治资源挖掘与利用的研究道路上坚持走下去。
来源:浙江大学